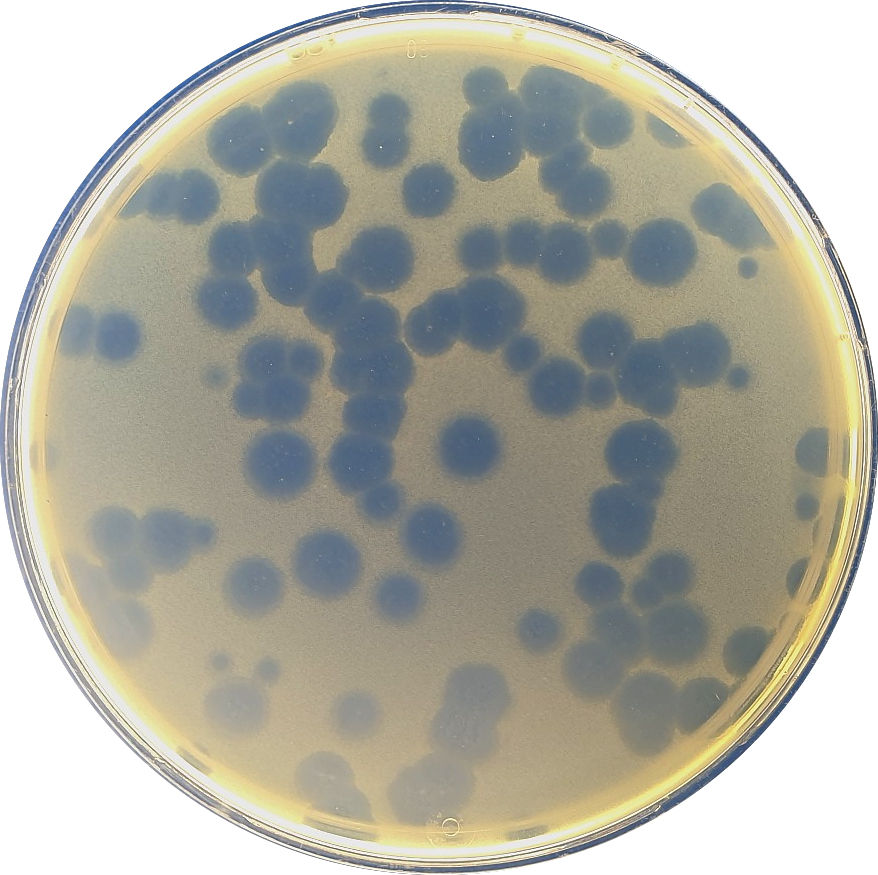
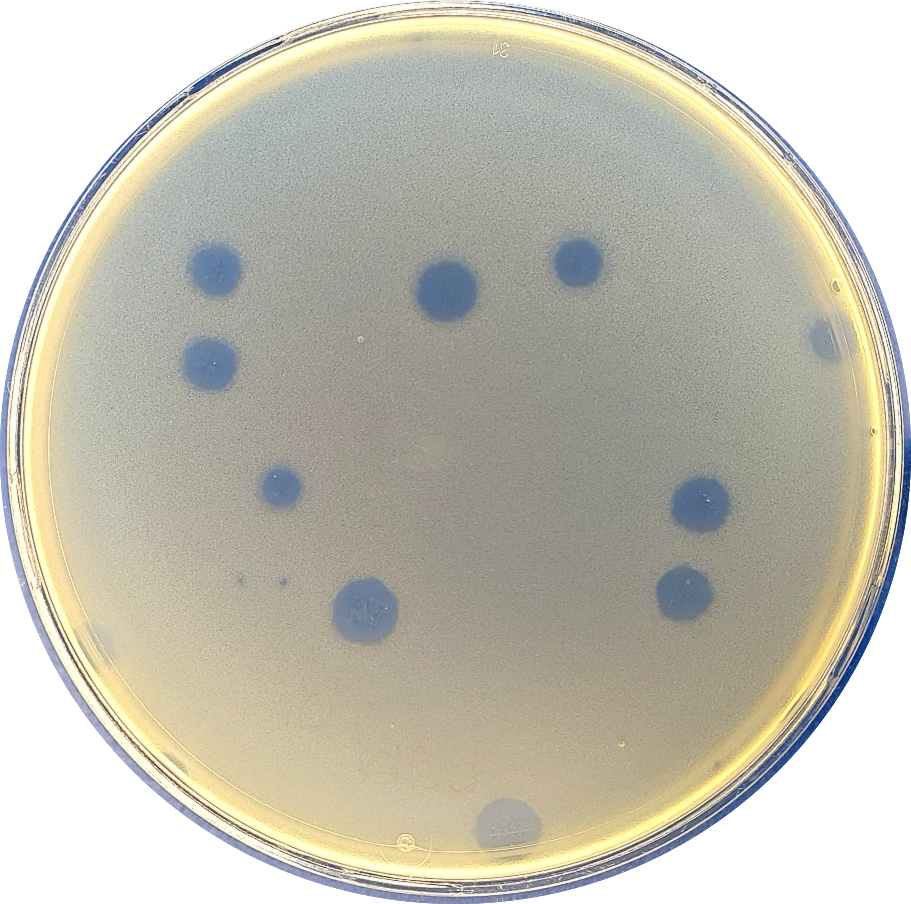
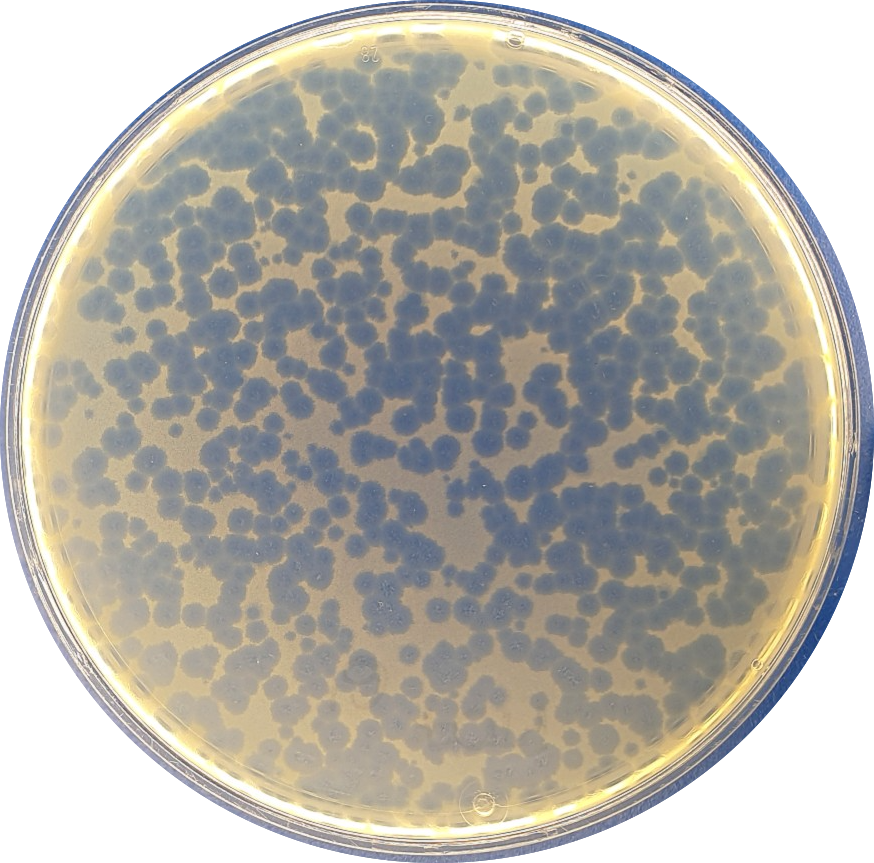

Fāgu pētniecības grupa
RSU fāgu pētniecisko grupu veido speciālisti, kuri ikdienā veic pētījumus par bakteriofāgu iespējamu lietošanu rezistentu bakteriālu infekciju profilaksē un ārstēšanā.
Fāgu grupas zinātniskās darbības fokuss ir vērsts uz tādām multirezistentām bakterijām kā K. pneumoniae, P. aeruginosa, E. coli, MRSA un citām. Tiek vērtēts bakteriofāgu lītiskais efekts baktēriju veidotajās biofilmās, kā arī bakteriofāgu iespējamās pielietošanas stratēģijas biofilmu asociētu infekciju ierobežošanā. Viens no zinātniskās darbības virzieniem ir pētīt un novērtēt bakteriofāgu mijiedarbību ar antibiotikām. Lai novērstu ar biomateriāliem asociētas infekcijas, tiek pētīti arī risinājumi, lai bakteriofāgus impregnētu biomateriālos.
Fāgu pētniecības grupas vadītāja
Prof. Juta Kroiča ir klīniskā mikrobioloģe, kura piedalās pētnieciskās grupas jaunu ideju veidošanā, rezultātu analīzē. Profesorei ir ilggadēja pieredze zinātnisko darbu organizēšanā un vadīšanā. Profesore grupas darbā pievēršas dažādu ar iespējamu fāgu lietošanu asociētu risku analīzē un izvērtēšanā.
Vadošais pētnieks
Dr. med. Kārlis Rācenis – prodekāns, internists, nefrologs, kurš vada grupas ikdienas darbu, vērtē pacientu klīniskās situācijas un bakteriofāgu terapijas iespējas konkrētiem pacientiem. Nodarbojas ar pētniecību, galvenokārt, vērtējot bakteriofāgu lītisko aktivitāti planktoniskās un biofilmu veidojošās baktērijās, kā arī pētot bakteriofāgu rezistences attīstību. 2023. gada decembrī aizstāvēja promocijas darbu Bakteriofāgu antibakteriālā darbība multirezistentās un biofilmu veidojošās infekcijās.
Pētnieku darba grupa
Dr. biol. Ņikita Zrelovs – pētnieks ar plašu prasmju kopumu, sākot no tradicionālajām mikrobioloģijas un molekulārās bioloģijas metodēm līdz bioinformātikai. Izmantojot multidisciplinārās pieejas, Ņikita līdz šim piedalījies vairāku desmitu agrāk nezināmu astaino bakteriofāgu izolēšanā un to īpašību aprakstīšanā ar mērķi paplašināt zināmo fāgu daudzveidību. Grupā Ņikita ir atbildīgs par mūsu laboratorijā izolēto fāgu, kā arī to saimnieku pilno genomu secību noskaidrošanu un analīzi.
Dr.sc.ing. Līga Stīpniece - vadošā pētniece un docente. Pateicoties vairāk kā desmit gadu zinātniskajai pieredzei biomateriālu pētniecībā, grupas ietvaros viņas kompetences joma ir biomateriālu sintēze un apstrāde lokālai un kontrolētai bakteriofāgu piegādei, lai novērstu ar biomateriāliem saistītas infekcijas.
Dr. Dace Rezevska – rezidente un doktorante klīniskajā mikrobioloģijā. Viņas zinātniskās darbības mērķis ir bakteriofāgu kā antimikrobiālu aģentu impregnēšana biomateriālos, lai šādus inovatīvus impregnētus materiālus izmantotu ar biomateriāliem asociētu infekciju profilaksē un ārstēšanā. Dace būtiski papildina grupas zinātnisko darbību ar ekspertīzi klīniskajā mikrobioloģijā. Šobrīd izstrādā promocijas darbu par bakteriofāgu impregnēšanu biomateriālos.
Laima Sevastjanova, MSc Clin. Pharm. – klīniskā farmaceite, kuras galvenie uzdevumi komandā ir pētīt un izvērtēt antibiotiku, bakteriofāgu un to kombināciju efektivitāti, kā arī sniegt farmaceitiskus ieteikumus pētnieku grupas zinātnisko metožu pilnveidošanā. Kā klīniskajam farmaceitam Laimai interesē meklēt jaunus risinājumus, lai uzlabotu ārstēšanas metodes izmantojot bakteriofāgus un to kombinācijas ar antibiotikām.
Lïse Berentsen, MSc Biomedicīnas zinātnē - pētniece ar starptautisku pieredzi gan mikrobioloģijā, gan molekulārajā bioloģijā. Viņai vienmēr bijusi plaša interese par dažādām bioloģijas jomām, un kopš bakalaura studijām viņa ir ieguvusi ievērojamu pētniecisko pieredzi, strādājot ar dažādiem mikroorganismiem. Viņas galvenais pētniecības virziens ir biofilmu veidojošo un multirezistento baktēriju apkarošana.
Mg.biol. Karīna Švānberga - Bioloģijas doktorantūras studente Latvijas Universitātē. Karīnas pētniecības pamatā ir zivīm patogēno Aeromonas ģints baktēriju inficējošo vīrusu izolēšana, raksturošana un dažādu fāgu-baktēriju mijiedarbības pētījumi, kas, iespējams, veidos jaunas zināšanas par fundamentālo fāgu bioloģiju un noderēs arī to pielietojumam praksē.
Sandis Mauriņš – Medicīnas fakultātes students, kurš interesējas par veidu, kā mazināt antibakteriālo rezistenci, kas pašlaik ir kļuvusi par globālu problēmu visā pasaulē. Mūsdienu medicīnā viņš saskata bakteriofāgu terapiju kā potenciālu alternatīvu, lai ārstētu multirezistentas bakteriālas infekcijas.
Nikola Brauča – Medicīnas fakultātes studente, kuras loma pētniecības komandā ir atrast, izdalīt un pavairot bakteriofāgus. Nikola sāka zinātniski pētniecisko darbību ar bakteriofāgiem jau skolas laikos un turpina attīstīties šajā jomā studiju laikā.
Renāte Rūta Apse – Medicīnas fakultātes studente ar padziļinātām interesēm par bakteriofāgu pielietojumu un efektivitāti pacientu ārstēšanā pret dažādiem rezistentiem baktēriju celmiem.
Kitija Straumane – biomedicīnas un pētījumu laborante, kas veic rezistento baktēriju jutību sagatavošanu ikdienā, biobankas krājuma papildināšanu fāgu tālākai izdalīšanai. Strādā klīniskajā universitātes slimnīcā, kā arī apgūst ārsta palīga specialitāti RSU Sarkanā Krusta medicīnas koledžā.

Fāgu pētniecības grupa RSU Zinātnes nedēļas 2025 laikā: Ņikita Zrelovs (no kreisās), Laima Sevastjanova, Renāte Rūta Apse, prof. Juta Kroiča, Doc.Kārlis Rācenis, Lise Berentsen, Līga Stīpniece, Dace Rezevska un Sandis Mauriņš

Lītiskais P. aeruginosa bakteriofāgs dubultā agara TSA plates

Attēlā redzams Siphovirus caurstarojošā elektronimikroskopijā

11 dažādu bakteriofāgu lītiskais efekts uropatogēnā E. coli
Jaunākās publikācijas un rezultāti
- Brauča, N., Rezevska, D., Jansons, J., Svanberga, K., Rācenis, K., Kroiča, J., & Zrelovs, Ņ. (2025). Isolation and Characterization of a Novel Klebsiella michiganensis Bacteriophage RSU-F4K5. PHAGE: Therapy, Applications, and Research. https://doi.org/10.1089/phage.2025.0009
- Rezevska, D., Stipniece, L., Rubene, L., Sceglova, M., Maurins, S., Vasiljevs, R., Racenis, K., & Kroica, J. (2025). Zinc-substituted hydroxyapatite–bacteriophage complexes for complementary antibacterial properties. Colloids and Surfaces A: Physicochemical and Engineering Aspects, 720, 137114. https://doi.org/10.1016/j.colsurfa.2025.137114
- Rīga Stradiņš University Phage Group. 2024. Klebsiella spp. strains from Latvia and their phages (BioProject PRJNA1199463). National Center for Biotechnology Information.
- Pirnay JP, Djebara S, Steurs G, Griselain J, Cochez C, De Soir S, Glonti T, Spiessens A, Vanden Berghe E, Green S, Wagemans J, Lood C, Schrevens E, Chanishvili N, Kutateladze M, de Jode M, Ceyssens PJ, Draye JP, Verbeken G, De Vos D, Rose T, Onsea J, Van Nieuwenhuyse B; Bacteriophage Therapy Providers; Bacteriophage Donors; Soentjens P, Lavigne R, Merabishvili M. Personalized bacteriophage therapy outcomes for 100 consecutive cases: a multicentre, multinational, retrospective observational study. Nat Microbiol. 2024 Jun;9(6):1434-1453. doi: 10.1038/s41564-024-01705-x. Epub 2024 Jun 4. PMID: 38834776; PMCID: PMC11153159
- Mauriņš, S., Rezevska, D., Sevastjanova, L., Kroiča, J., & Rācenis, K. (2023). Perspektīvas antimikrobiālās rezistences pārvarēšanā: bakteriofāgu potenciāla izmantošana mūsdienu medicīnā. Latvijas Ārsts, (Nr.9/12), 94-100
- Racenis K, Lacis J, Rezevska D, Mukane L, Vilde A, Putnins I, Djebara S, Merabishvili M, Pirnay JP, Kalnina M, Petersons A, Stradins P, Maurins S, Kroica J. Successful Bacteriophage-Antibiotic Combination Therapy against Multidrug-Resistant Pseudomonas aeruginosa Left Ventricular Assist Device Driveline Infection. Viruses. 2023 May 20;15(5):1210. doi: 10.3390/v15051210. PMID: 37243293; PMCID: PMC10223274
- Grase L, Onufrijevs P, Rezevska D, Racenis K, Skadins I, Karosas J, Gecys P, Iesalnieks M, Pludons A, Kroica J, Raciukaitis G. Effect of Femtosecond Laser-Irradiated Titanium Plates on Enhanced Antibacterial Activity and Preservation of Bacteriophage Stability. Nanomaterials (Basel). 2023 Jul 9;13(14):2032. doi: 10.3390/nano13142032
- Mukane L, Racenis K, Rezevska D, Petersons A, Kroica J. Anti-Biofilm Effect of Bacteriophages and Antibiotics against Uropathogenic Escherichia coli. Antibiotics (Basel). 2022;11(12):1706. Published 2022 Nov 26. doi:10.3390/antibiotics11121706
- Racenis K, Rezevska D, Madelane M, et al. Use of Phage Cocktail BFC 1.10 in Combination With Ceftazidime-Avibactam in the Treatment of Multidrug-Resistant Pseudomonas aeruginosa Femur Osteomyelitis-A Case Report. Front Med (Lausanne). 2022;9:851310. Published 2022 Apr 25. doi:10.3389/fmed.2022.851310
- Stipniece L, Rezevska D, Kroica J, Racenis K. Effect of the Biopolymer Carrier on Staphylococcus aureus Bacteriophage Lytic Activity. Biomolecules. 2022;12(12):1875. Published 2022 Dec 14. doi:10.3390/biom12121875
- Racenis K, Kroica J, Rezevska D, et al. S. aureus Colonization, Biofilm Production, and Phage Susceptibility in Peritoneal Dialysis Patients. Antibiotics (Basel). 2020;9(9):582. Published 2020 Sep 7. doi:10.3390/antibiotics9090582
Projekti
Vairāk par fāgu pētniecību RSU
Meklē jaunas metodes cīņai pret grūti ārstējamām infekcijām
Bakteriofāgi: kas par šiem organismiem izpētīts Latvijā un kā tie var palīdzēt
Disertācijas pētījums par fāgu jeb baktēriju vīrusu efektu bakteriālo infekciju ārstēšanā
Pēdējā iespēja – kā bakteriofāgu pētījumi Latvijā palīdz glābt dzīvības
Neparastie vīrusi: baktēriju iznīcinātāji – bakteriofāgi
Kārlis Rācenis ar kolēģiem rada alternatīvu antibiotikām
Kad antibiotikas vairs nestrādā, palīgā nāk fāgi
Bakteriofāgu terapija. Kā baktēriju «apēdāji» var palīdzēt infekciju ārstēšanā
VIDEO: Labie vīrusi – medicīnas nākotne?
Darbinieki
Fāgu pētniecības grupa
Saistītās ziņas
RSU tenūrprofesore Maija Radziņa pārstāv Latviju ES vēža skrīninga un agrīnās diagnostikas politikas samitā BriselēPētniecība, Starptautiskā sadarbība
Zinātnieki ilgstošu sēdēšanu salīdzina ar smēķēšanu. Ko RSU pētījumi atklāj par biroja darbinieku veselībuPar mums medijos, Iekšējā konsolidācija, Pētniecība
Sporta psiholoģijas pētījums par jauniešu sportistiem. Kā izdegšana, trauksme un labbūtība veido atšķirīgus sportistu profilusPētniecība, Psiholoģija
Zinām, bet nedarām. Kā psiholoģiskie faktori ietekmē sirds un asinsvadu pacientu līdzestībuPētniecība, Psiholoģija








